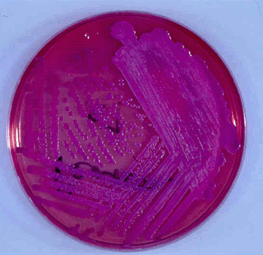

Epidemiology
Melioidosis is an emerging infectious disease that is endemic in South-East Asia and the 'Top End' of Australia. Melioidosis represents the most common cause of fatal community-acquired septicaemia and pneumonia in parts of north-eastern Thailand as well as at the Royal Darwin Hospital1,2; these areas are considered hyper-endemic for melioidosis. However, emerging data indicate that the geographic distribution of melioidosis may be far wider than previously suspected3. There is evidence suggesting it is now endemic in the Indian subcontinent, southern China, Hong Kong and Taiwan, as well as reports of sporadic cases in Africa, the Americas, the Middle East and island communities in the Pacific and Indian oceans3. Low levels of sporadic infection, with peaks at times of high rainfall, are seen in endemic areas. Outbreaks and case clusters occur but are rare. Occasional foci of infection have occurred in subtropical and temperate regions, such as the one human and several veterinary cases occurring near Perth, Western Australia, in the early 1990s4 and a case report from south-eastern Queensland5. An outbreak of human and veterinary cases of melioidosis, associated with zoos and equestrian clubs, was recorded in France during the 1970s6. It remains uncertain whether the occurrence of melioidosis has increased in recent years, or whether it was simply previously under-diagnosed and under-recognised by clinicians.
Studies conducted between 1989 and 2003 have shown an increasing incidence of melioidosis in the Top End of Australia7,8. This compares with an increase from 4.4 per 100 000 (1987-1991) to 21.3 per 100 000 in 2006 in Ubon Ratchatani province, Thailand9. Rainfall in particular seems to have an important role in the disease: incidence rose from 16.5 to 34.5 cases per 100 000 people in the Top End over the very heavy 1997-1998 wet season, and severity of the disease increased significantly9,10. Most recently, incidence reached record rates (50.2 cases per 100 000 people) over the 2009-2010 wet season, which was again associated with heavy rainfall11.
Environment
Melioidosis is caused by the bacterium Burkholderia pseudomallei, a soil and freshwater saprophyte. It was first discovered by Alfred Whitmore and C.S. Krishnaswami amongst morphine addicts in Burma in 191112,13. Although initially classified in the genus Pseudomonas, it was reclassified under a new genus, Burkholderia, in 1992. The organism has been recovered from wet soils, streams, pools, stagnant water and rice paddy fields in particular. The demonstration of B. pseudomallei survival within spores of mycorrhizal fungi14 and environmental amoebae15 has led to the proposal that these soil organisms may represent a niche for survival and dissemination in the natural environment.
The commonest mode of transmission is via direct inoculation of contaminated soil and surface water through skin abrasions. Human-to-human transmission, transmission through inhalation of polluted water and contact with contaminated ground water have been reported16-18. The disease affects a wide range of susceptible animals, including cats, goats, sheep and horses19,20. Zoonotic transmission is reported to be rare, with only three possible cases being reported in Australia19.
Risk factors
The prevalence of melioidosis is highest amongst immunocompromised individuals and those with significant comorbidities. Diabetes mellitus is the most important host risk factor for the disease21,22, with one study finding 60.9% of affected patients had diabetes mellitus21. Other high-risk populations include individuals with chronic renal impairment (present in 12% of cases), pulmonary disease (27% of cases)2, thalassaemia22, congestive heart failure, corticosteroid therapy, malignancy (particularly leukaemia and lymphoma) and immunosuppression20. It is significantly associated with prolonged alcohol intake, with a history of alcohol abuse evident in 39% of cases in Australia's Northern Territory20; and in 12% of melioidosis cases in Thailand21. Ingestion of kava (a plant-based relaxant) has also been linked to an increased risk of contracting melioidosis, with 8% of cases in Northern Australia attributed to high rates of kava consumption2. The first four cases of melioidosis reported in New Caledonia occurred between 1999 and 2004, and interestingly all four individuals were heavy consumers of kava22.
Continual occupational exposure to soils and ground water contributes to an increased risk of contracting melioidosis, placing rice farmers and labourers at greater risk23. Additionally, infection can also occur indirectly through contamination of generally harmless materials. A case in the Northern Territory reported two mechanics infected with B. pseudomallei from contaminated handwashing detergent, due to the introduction of a hose that had been contaminated by nearby soil24. Similar cases have been reported of melioidosis from contaminated chlorhexidine antiseptic wash24.
Melioidosis can also occur in healthy and low-risk individuals25. While it is most prevalent in those in the fourth and fifth decades of life26, the disease can affect persons of all ages including children27. A Thai study found that 36% of melioidosis cases studied occurred in otherwise healthy, low-risk patients28. A study conducted in the Northern Territory found that as many as 20% of symptomatic hosts were considered to be at low risk of the disease; one death was reported2. Individuals with no risk-factors experience less-severe symptoms and fatalities are rare25.
If patients present to their health practitioner with a history of recent travel or residence in a B. pseudomallei endemic region - particularly in the wet season; and if they possess predisposing host-factors such as diabetes mellitus, chronic renal failure or a history of alcohol abuse - melioidosis must be considered. A low clinical threshold for a diagnosis of melioidosis in such patients will result in early treatment and mitigation of disease severity25.
Clinical features
There are a variety of classifications for the clinical presentations of melioidosis29-31. Melioidosis is divided into acute, subacute and chronic cases as suggested by Howe et al29. Another classification method divided the disease presentations into disseminated septicaemic melioidosis, non-disseminated septicaemic melioidosis, localised melioidosis, transient bacteremia, probable and subclinical melioidosis30. Severe melioidosis may present as a disseminated septicaemic, non-disseminated septicaemic or localised infection. The wide range of possible presentations often means that melioidosis represents a diagnostic challenge, particularly for those who may not encounter the disease on a frequent basis.
Subclinical
Most people exposed to the bacteria do not have any clinical symptoms. In endemic areas seroconversion occurs once children are exposed to wet soil (about 25% seroconvert annually between 6 months and 4 years), resulting in high rates of seropositivity32,33. However the relevance of this in terms of a future clinical disease due to a latent focus is still quite unclear, although Currie et al. state that most cases are a result of recent acquisition, not re-activation34.
Acute
Acute cases are those where symptoms were present for less than 2 months. In most patients, mean incubation was 9 days (range 1-21 days), although cases up to 62 years after initial exposure have been reported35. The spectrum of clinical presentations range from the severe, fulminant disease (such as multi-organ abscesses) to asymptomatic or minor localised infections. The type of presentation may be influenced by the magnitude of exposure, mode of acquisition, host factors and risk factors. Melioidosis may present as pneumonia, skin abscesses, internal organ abscess, osteomyelitis, septic arthritis and even encephalomyelitis2. Almost any organ system may be affected, including the lungs, kidneys, prostate, skin, liver, parotids and the brain20,36,37. In the Australian context, acute melioidosis accounts for a large majority of presentations (up to 91% compared to 9% for chronic disease)38. It is interesting to note that B. pseudomallei prostatic abscesses (Fig1), which had been thought of as uncommon, have been shown to be prevalent in Australian patients37,39. This range of unusual pathologies due to melioidosis demonstrates the need to perform extensive investigations in affected patients.
Pneumonia is the most common presentation of melioidosis, accounting for roughly half of all cases (Fig2). This finding is consistent across a wide variety of studies in different areas2,20,38,40-43, and is more commonly due to haematogenous dissemination to the lungs rather than inhalation of the pathogen44. The severity of the condition varies widely, from septic shock to mild undifferentiated pneumonia. Septic shock patients may present acutely unwell with high fevers and only slight cough or pleuritic pain, whereas patients with undifferentiated pneumonia will present with a more predominant cough accompanied by sputum and dyspnoea44. Radiography may range from diffuse nodular infiltrates in both lungs of septic shock patients to discrete and progressive consolidation in one or more lobes for those with undifferentiated pneumonia. It is most commonly found in the upper lobes, and pleural effusions and empyema may occur, particularly with lower lobe disease41,45. Melioidosis may be mistaken for tuberculosis and thus a high index of suspicion is required, particularly when encountering such cases in endemic areas. B. pseudomallei pneumonia is often associated with disseminated disease, causing septic shock and multi-organ dysfunction.
Chronic
Chronic melioidosis is defined as an illness where symptoms have lasted for longer than 2 months at presentation2. Patients present with a chronic respiratory illness that mimics tuberculosis, displaying signs such as fevers, weight loss and a productive cough with or without haemoptysis. There are often long-standing abscesses involving multiple sites as well.
Latency
At one point, latent melioidosis was referred to as the 'Vietnam time bomb'46, alluding to its potential to remain latent for long periods of time in returned servicemen from Vietnam28. Delays from primary exposure to active disease of up to 62 years have previously been reported35. This long period in between acquisition and clinical presentation may be due to a decrease in host immunocompetence (particularly with comorbidities such as diabetes mellitus, renal failure and alcoholism). Therefore, melioidosis cannot be excluded as a potential diagnosis in those who have not travelled to endemic areas for many years.
 Figure 1: MRI showing Burkholderia pseudomallei prostatic abscess (courtesy Dr Robert Norton, Director of Pathology, Townsville Hospital).
Figure 1: MRI showing Burkholderia pseudomallei prostatic abscess (courtesy Dr Robert Norton, Director of Pathology, Townsville Hospital).
 Figure 2: Chest X-ray showing left upper lobe pneumonia caused by Burkholderia pseudomallei (courtesy Dr Robert Norton, Director of Pathology, Townsville Hospital).
Figure 2: Chest X-ray showing left upper lobe pneumonia caused by Burkholderia pseudomallei (courtesy Dr Robert Norton, Director of Pathology, Townsville Hospital).
Biological warfare
B. pseudomallei has been labelled a category B priority pathogen by the United States Centers for Disease Control and Prevention (CDC). The organism has been the source of international concern in the past, as a source of both interest and concern as a 'potential bioterror agent'. Its properties have been investigated by the USA and potentially Iran, Iraq, North Korea and Syria28. Unlike most other bacteria, B. pseudomallei is readily available in the environment; it is simple and cost-effective to produce28 with considerable potential for infectivity and transmission, particularly via inhalation of aerosolised bacteria20; and it is resistant to standard antibiotic treatments for community-acquired pneumonia. Furthermore, at present B. pseudomallei lacks an effective vaccine47. This, combined with its capacity to cause severe disease if a bacteraemia ensues, allows it a significant potential for high rates of morbidity and mortality.
Despite these properties and international concern, B. pseudomallei has never yet been utilised in biological warfare48, and the effectiveness of the bacteria as such an agent is not fully understood46. Whilst release amongst healthy military troops without underlying chronic disease may not result in mass casualties, those clinical cases that did occur, and the potential for latent disease in exposed soldiers, would affect morale. Release into a civilian population would result in higher casualties and potentially greater effects on morale.
Diagnostic investigations
A diagnosis of melioidosis can be a very difficult, particularly when it occurs outside of endemic regions. The definitive diagnosis is made when B. pseudomallei is recovered from any site - it is never normal flora. Complete screening of patients is recommended (blood, sputum, urine, pus culture and throat swab)49-52, and a frequent oversight is to only order specimens from the affected site. Imaging, though not diagnostic of the disease, is often very useful to ascertain the extent of the disease. CT scans or ultrasound of the abdomen is recommended routinely to check for subclinical abscesses, particularly of the prostate, which is an area with a high incidence of abscesses in northern Australia52,53.
Laboratory diagnosis
B. pseudomallei is an aerobic, oxidase positive, Gram negative bacillus. A vacuole in the centre of the cell leads to a 'safety pin' appearance in Gram stain54. The organism will grow on non-selective agar, most commonly forming small, smooth colonies with a metallic sheen and strong soil smell after 24 to 48 hours. After 3-5 days, colonies become dry and wrinkled (Fig3), resembling Pseudomonas stutzeri. Isolates are generally resistant to colistin and gentamicin54, but sensitive to amoxicillin/clavulanate55. Mucoid phenotype and gentamicin sensitive strains have been previously identified54. B. pseudomallei is a biosafety level 3 pathogen, requiring specialised laboratory handling26.
 Figure 3: Burkholderia pseudomallei colonies grown on blood agar after several days incubation; note the distinctive 'crinkled' colonial morphology (image from http://micrognome.priobe.net, reproduced with permission of Professor Tim Inglis).
Figure 3: Burkholderia pseudomallei colonies grown on blood agar after several days incubation; note the distinctive 'crinkled' colonial morphology (image from http://micrognome.priobe.net, reproduced with permission of Professor Tim Inglis).
Selective media
The most commonly employed selective agar for B. pseudomallei is Ashdown's medium. The primary selective is gentamicin56, excluding the growth of rare gentamicin sensitive strains of B. pseudomallei56. Colonies on Ashdown's medium will grow within 72 h incubation in air at 37°C (with the exception of ceftazidime resistant mutants), and have a purple colour due to the neutral red indicator (Fig4). Ashdown's selective broth with colistin may be used to enhance the recovery of B. pseudomallei from throat and other non-sterile site specimens57.
Francis medium, a modification of Ashdown's medium, with an increase in gentamicin concentration from 4 mg/L to 8 mg/L and the neutral red indicator replaced with bromocresol purple, has been described58. The bromocresol purple indicator in Francis medium results in yellow-coloured colonies of B. pseudomallei. Gentamicin resistant Klebsiella and Escherichia coli colonies will also produce yellow colonies on this medium, but their negative oxidase reaction should easily exclude these from further investigation. A comparative study of Francis and Ashdown's medium using spiked sputum samples found a slightly improved sensitivity for Francis medium (76.7% vs 73.3%); 95% comparative confidence intervals for this study were not published58.
Laboratories outside of endemic areas that do not stock Ashdown's medium may use Burkholderia cepacia selective agar (BCSA) or Pseudomonas selective agar (PSA) as an alternative when specimens for B. pseudomallei investigation are occasionally submitted. One comparative study found that 70% of B. pseudomallei strains (originally recovered on Ashdown's agar) grew on BCSA, whilst 95% were detected on PSA59. Growth of Pseudomonas aeruginosa limits the utility of PSA as a selective agar for environmental samples or human specimens containing this organism. A separate study comparing Ashdown's agar, BCSA and B. pseudomallei selective agar (BPSA) found no significant difference in sensitivity for B. pseudomallei in all three media60.
Figure 4: Burkholderia pseudomallei colonies grown on Ashdown's agar after 2 days incubation (courtesy Dr Robert Norton, Director of Pathology, Townsville Hospital).
Figure 4: Burkholderia pseudomallei colonies grown on Ashdown's agar after 2 days incubation (courtesy Dr Robert Norton, Director of Pathology, Townsville Hospital).
Phenotypic identification
The laboratory identification of B. pseudomallei remains problematic, particularly in laboratories without regular exposure to this organism. Isolation of an organism with colonial morphology resembling B. pseudomallei from a patient with relevant clinical notes should elicit suspicion, regardless of the length of time since that patient has visited an endemic area. The strong soil smell of B. pseudomallei colonies was a historically used method of screening suspicious oxidase positive colonies, but occupational health and safety considerations disallow this.
Biochemical profile alone is insufficient to definitively identify an unknown oxidase positive Gram negative bacillus as B. pseudomallei. The most common biotypes for B. pseudomallei yielded by the API 20NE identification system are 1156576 and 1156577, a small number (7%) differing from these biotypes only in negative results for aesculin hydrolysis61. The Vitek 2 and WalkAway 96 systems showed respective sensitivities of 69% and 96% for the identification of B. pseudomallei with low discrimination identifications by the Vitek 2 common62. Whilst the API 20NE correctly identified 87.0% of 5663 and 99.0% of 800 test isolates61 respectively in two studies. It should be considered that the isolates tested in these studies were probably originally identified as B. pseudomallei by biochemical means. Another study comparing API 20NE results with molecular testing found that only 37% of API 20NE results correctly identified B. pseudomallei after 48 h incubation54.
Matrix-assisted laser desorption/ionization of time-of-flight mass spectrometry (MALDI-TOF MS) has shown potential for rapid detection of B. pseudomallei at a low cost64. In order to identify B. pseudomallei using the MALDI-TOF system, a MALDI Biotyper Security Reference Library must be installed on the analyser. A recent paper by Inglis et al. described both the development of an in-house B. pseudomallei mass spectra pattern library employing 43 isolates identified by lpxO PCR assay and gas-liquid chromatography bacterial fatty acid methyl ester analysis. Employment of this library in clinical practice led to the detection of B. pseudomallei directly from the positive blood cultures of two patients64.
Non-commercial monoclonal antibody solutions have been successfully employed in initial B. pseudomallei screening. When compared to a semi-nested PCR as a reference method, monoclonal antibody testing after 24 h growth yielded positive results for 87% of 71 PCR positive isolates. This rose to 94% of PCR positive isolates being correctly identified using monoclonal antibodies when 48 h colonies were tested54. It should be noted that cross-reaction of the monoclonal antibody reagent with Burkholderia multivorans and Burkholderia thailandensis was observed in this study54.
Cellular fatty acid analysis using 2-hydroxymyristic acid as a marker for B. pseudomallei has shown moderate success54, although the need for specialised gas-liquid chromatographs, cross-reactions with B. cepacia, 3 day delay for results and the need to repeat tests on some occasions render this method impractical for most laboratories.
Two species that may act as confounders to the identification of B. pseudomallei in the laboratory are Burkholderia oklahomensis and Burkholderia thailandensis65,66. Both represent environmental organisms almost identical biochemically and morphologically to B. pseudomallei, but not significantly associated with human disease, and rarely are they encountered in clinical specimens62. B. thailandensis may be differentiated from B. pseudomallei by its capacity to assimilate arabinose67. However, B. oklahomensis requires molecular approaches to be differentiated from B. pseudomallei62.
Highly resistant small-colony variants of B. pseudomallei have previously been induced in vitro, but have not yet been detected in any clinical infections68. However, a recent concerning development was the isolation of ceftazidime resistant variants of B. pseudomallei with abnormal growth defects that negate their growth on routine non-selective agars. Such variant strains were isolated alongside wild-type B. pseudomallei from several patients unresponsive to ceftazidime therapy69. These variants do not grow on blood or MacConkey agars and grow only slowly on Ashdown's medium (it is thought that the buffering effect of glycerol in Ashdown's medium allows growth). Colonies are pinpoint size after 48 h growth on Ashdown's agar, and do not grow sufficiently quickly for biochemical identification; therefore, a molecular approach is required69.
Molecular detection and identification
A number of PCRs have been described in the literature70-72. Merritt et al. compared three novel PCR assays (once conventional and two real-time assays) using a previously published semi-nested conventional real-time PCR as the reference method70. A Taqman PCR directed against lpxO was identified as the most sensitive and specific assay70.
Two Taqman real-time PCR assays developed in Thailand (designated 8653 and 9438) showed 100% specificity and sensitivity when tested against bacterial extracts and crude lysates. When these two PCRs were used to detect B. pseudomallei in clinical sputum and blood specimens, PCR 8653 showed superior sensitivity, particularly in fatal cases71. The findings of the study highlight the need to determine sensitivity and specificity of PCR detection in clinical isolates and not bacterial lysates or spiked samples.
Serology
The most sensitive serological test for antibodies to B. pseudomallei available at present is the indirect haemagglutination assay73. However, sensitivity is adversely affected by high background prevalence of positive antibodies in endemic areas, and thus the diagnostic cut-off varies based on local prevalence of melioidosis. In Australia, this is set at a level of ≥1:40 (with a 56% sensitivity), compared against 1:160 in north-eastern Thailand (with a 72% sensitivity)74. In Thailand, a specific direct immunofluorescent antibody test (IFAT) and latex agglutination is available but this is not commonly used in Australia75-78. The latex agglutination test performed well in a small sample volume study (n=30 isolates) comparing the test to PCR, with 100% correlation in results found55. In a separate and much larger study (n=800 isolates), 99.5% of B. pseudomallei isolates reacted in the latex agglutination test. The test was negative for 120 other oxidase positive, Gram negative bacilli. The test did not differentiate between B. mallei and B. pseudomallei, and the methods used by contributing laboratories to identify submitted B. pseudomallei were not stated61. A whole-cell antigen IFAT derived from B. thailandensis performed well when compared to B. pseudomallei whole-cell antigen IFAT, with advantages for assay preparation due to the low pathogenicity of B. thailandensis76. This highlights the possibility that prior patient exposure to soil organisms similar to B. pseudomallei, such as B. thailandensis, may result in false positive serosurvey results. The need to apply caution in the interpretation of serological results when employing unvalidated ELISA methods was recently highlighted by Peacock et al73..
Controversies in laboratory identification
The ideal method of B. pseudomallei identification is unclear. Whilst some studies show a high accuracy of biochemical tests combined with simple screening tests61,79,80, this has been called into question by other studies54,63,80. There is significant interstudy variation in results, and some authors now suggest that biochemical testing panels have a limited role in B. pseudomallei identification due to the low sensitivity of this methodology54.
There is evidence showing that monoclonal antibody-based latex agglutination tests have excellent sensitivity and specificity55,61,81-83, with the exemption of urine antigen testing, which has been shown to have 100% specificity but low sensitivity75. Only one study reported a lower sensitivity compared to PCR identification methods54. This tends to be more cost-effective and is routinely used in endemic areas. However in non-endemic regions where laboratory technicians lack experience in identifying B. pseudomallei and latex agglutination tests will not be routinely available in diagnostic labs, positive identification of a suspected isolate can be difficult.
A 'gold standard' identification method has not yet been determined; it would assist greatly in addressing the above controversies84. Molecular testing has shown excellent sensitivity and specificity, and is gaining wider acceptance due to its rapid rate of detection84,85. Furthermore, differentiating between B. pseudomallei and closely related species such as B. mallei and B. thailandensis has been shown to be an issue in the past with other diagnostic techniques - molecular techniques allow us to address this issue86,87. They can also reduce exposure of lab personnel to the pathogen when compared to more conventional diagnostic methods82. However, molecular methods are not always readily available, particularly in developing countries. Also, random mutation of the primer binding site may lead to unreliable results with molecular techniques. A recently employed method of identification is the use of MALDI-TOF MS; however, it is crucial to expand the existing databases with pathogens endemic to different regions, because the current commercial databases may result in rare instances of species misidentification88.
Clinical treatment
Clinical management has two main phases: the intravenous intensive phase for treatment of acute disease, followed by the eradication phase. At the moment, intravenous ceftazidime (2 g, 6 hourly) or meropenem (1 g, 8 hourly) plus high-dose cotrimoxazole are the drugs of choice in Australia, and it is usually administered for at least 14 days89,90. One of the problems with melioidosis is that it is intrinsically resistant to many broad-spectrum antibiotics (such as penicillin, ampicillin, gentamicin, streptomycin, and first- and second-generation cephalosporins). Most strains are, however, sensitive to newer beta-lactams, ceftazidime, imipenem, meropenem, piperacillin, amoxycillin-clavulanate, ceftriaxone and cefotaxime. Prior to 1989, conventional therapy was often a combination of various drugs (chloramphenicol, cotrimoxazole, doxycycline, trimethoprim, sulfamethoxazole) given for 6 weeks to 6 months. Ceftazidime was associated with a significantly lower rate of mortality in severe melioidosis91. In a comparison trial, the overall therapeutic failure rate was significantly higher for those treated with amoxicillin-clavulanate92. It was concluded that whilst amoxicillin/clavulanate was a safe and effective initial treatment, ceftazidime was the treatment of choice for severe melioidosis92. The addition of cotrimoxazole did not confer a short nor long-term benefit93,94. Cefoperazone/sulbactam has been compared against ceftazidime as adjunctive therapy to cotrimoxazole, and there was no significant difference between mortality rate, duration of defervescence and bacteriological response in the two treatment arms95. Antibiotics other than ceftazidime may be used as a second-line therapy where first-line treatment options are unavailable or contraindicated96,97. Resistance to ceftazidime, amoxicillin-clavulanate and carbapenems in clinical cases is rare, and issues with resistance are more pertinent in eradication therapy90,98,99. In Australia, carbapenems (imipenem and meropenem) are alternatives to ceftazidime as first-line therapy. This was initiated after they were shown to be highly active in vitro100-102. It has been shown that there was no difference in overall or short-term survival and that treatment failure may be more common in those with ceftazidime alone103. Further research is required to investigate if meropenem is indeed of higher efficacy than ceftazidime, and the ATOM (Acute Treatment of Melioidosis) trial is currently under way to address this issue (US National Institutes of Health ClinicalTrials Identifier NCT00579956).
Eradication therapy
Three months of oral antibiotic therapy is usually the minimum for the eradication phase, and this is further lengthened in severe infections. In the past, a four-drug regimen (trimethoprim, sulfamethoxazole, doxycycline, chloramphenicol) was employed. This regimen was not well tolerated, which led to low adherence to therapy. It has been shown that in patients who survive the initial disease, choice and duration of antibiotic therapy is the most important determinant of relapse, with up to 90% decreased risk of relapse in those who adhere to an appropriate regimen for 12-16 weeks versus 8 weeks104. In Australia, the drug of choice is oral monotherapy with high-dose cotrimoxazole (320 mg of trimethoprim and 1600 mg of sulphamethoxazole, 12 hourly), whereas in Thailand a weight-based dosing protocol has now come into effect (<40 kg body weight, 160/800 mg; 40-60 kg, 240/1200 mg; >60 kg, 320/1600 mg - all 12 hourly), in combination with doxycycline (100 mg, 12 hourly)90,91,105. If this cannot be tolerated, or is contraindicated, amoxicillin-clavulanate (500 and 125 mg respectively, 8 hourly) is employed, using a weight-based dosing protocol (20 mg and 5 mg respectively/kg, thrice daily)96,106,107. Resistance to cotrimoxazole in B. pseudomallei does occur, although this is quite rare in Australia (2.5% of clinical isolates)96 in comparison with other areas (13-16% in Thailand)108,109. Resistance over the course of therapy has also been documented, and this can be quite difficult to manage because there is often cross-resistance to other agents109.
Post-exposure prophylaxis may be considered in some cases, particularly in accidental laboratory exposure. However, it must be noted that evidence for efficacy in humans is lacking. In animal models it has been shown that animals receiving cotrimoxazole had a 100% survival rate if it was given within 24 h. Currently it is thought that cotrimoxazole (320 mg of trimethoprim and 1600 mg of sulphamethoxazole, 12 hourly for 3 weeks)90 would be the best first-line agent, with doxycycline and amoxicillin-clavulanate as alternatives.
Conclusions
Our understanding of melioidosis has come a long way since the discovery of the disease nearly 100 years ago by Whitmore. However, it continues to be a lethal disease causing considerable mortality and morbidity in hyper-endemic areas. Increasing prevalence combined with the fact that a highly effective treatment has not yet been found makes it an important public health entity in these countries. Continued education and clinical awareness by medical professionals operating in endemic countries or working with those returning from endemic areas remains the most effective means by which to ensure timely identification and appropriate management of cases of melioidosis.
References
1. Limmathurotsakul D, Wongrattanacheewin S, Teerawattanasook N, Wongsuvan G, Chaisuksant S, Chetchotisakd P, et al. Increasing incidence of human melioidosis in northeast Thailand. American Journal of Tropical Medicine and Hygiene 2010; 82: 1113-1117.
2. Currie B, Fisher D, Howard D, Burrow J, Lo D, Selvanayagam S, et al. Endemic melioidosis in tropical Northern Australia: a 10-year prospective study and review of the literature. Clinical Infectious Diseases 2000; 31: 981-986.
3. Currie B, Dance D, Cheng A. The global distribution of Burkholderia pseudomallei and melioidosis: an update. Transactions of the Royal Society of Tropical Medicine and Hygiene 2008; 102: S1-S4.
4. Golledge C, Chin W, Tribe A, Condon R, Ashdown L. A case of human melioidosis originating in south-west Western Australia. Medical Journal of Australia 1992; 157: 332-334.
5. Guard R, Morero P, Yi W, Mackay M. Melioidosis in south-eastern Queensland. Medical Journal of Australia 2009; 191: 290.
6. Dance D. Melioidosis as an emerging global problem. Acta Tropica 2000; 5: 115-119.
7. Currie B, Fisher D, Howard D, Burrow J, Selvanayagam S, Snelling P, et al. The epidemiology of melioidosis in Australia and Papua New Guinea. Acta Tropica 2000; 74: 121-127.
8. Currie B, Jacups S, Cheng A, Fisher D, Anstey N, Huffam S, et al. Melioidosis epidemiology and risk factors from a prospective whole-population study in northern Australia. Tropical Medicine and International Health 2004; 9: 1167-1174.
9. Supputtamongkol Y, Hall A, Dance D, Chaowagul W, Rajchanuvong A, Smith M, et al. The epidemiology of melioidosis in Ubon Ratchatani, northeast Thailand. International Journal of Epidemiology 1994; 23: 1082-1090.
10. Currie B, Jacups S. Intensity of rainfall and severity of melioidosis, Australia. Emerging Infectious Diseases 2003; 9: 1538-1542.
11. Parameswaran U, Baird R, Ward L, Currie B. Melioidosis at the Royal Darwin Hospital in the big 2009-2010 wet season: comparison with the preceding 20 years. Medical Journal of Australia 2012; 196: 345-348.
12. Whitmore A. An account of a glanders-like disease occurring in Rangoon. The Journal of Hygiene 1913; 13: 1-34.
13. Whitmore A, Krishnaswami C. An account of the discovery of a hitherto undescribed infective disease occurring among the population of Rangoon. Indian Medical Gazette 1912; 47: 262-267.
14. Levy A, Chang B, Abbot L, Kuo J, Harnett G, Inglis T. Invasion of spores of the Arbuscular Mycorrhizal Fungus Gigaspora decipiens by Burkholderia spp. Applied and Environmental Microbiology 2003; 69: 6250-6256.
15. Inglis T, Rigby P, Robertson T, Dutton N, Henderson M, Chang B. Interaction between Burkholderia pseudomallei and Acanthamoeba species results in coiling phagocytosis, endamebic bacterial survival, and escape. Infection and Immunity 2000; 68: 1681-1686.
16. Currie B, Mayo M, Anstey N, Donohue P, Haase A, Kemp D. A cluster of melioidosis cases from an endemic region is clonal and is linked to the water supply using molecular typing of Burkholderia pseudomallei isolates. American Journal of Tropical Medicine and Hygiene 2001; 65: 177-179.
17. Kunakorn M, Jayanetra P, Tanphichitra D. Man-to-man transmission of melioidosis. Lancet 1991; 337: 1290-1291.
18. Ralph A, McBride J, Currie B. Transmission of Burkholderia pseudomallei via breast milk in northern Australia. Pediatric Infectious Disease Journal 2004; 23: 1169-1171.
19. Choy J, Mayo M, Janmaat A, Currie B. Animal melioidosis in Australia. Acta Tropica 2000; 74: 153-158.
20. Currie B, Ward L, Cheng A. The epidemiology and clinical spectrum of melioidosis: 540 cases from the 20 year Darwin prospective study. PLoS Neglected Tropical Diseases 2010; 4: e900.
21. Suputtamongkol YCW, Chetchotisakd P, Lertpatanasuwun N, Intaranongpai S,Ruchutrakool T, Budhsarawong D, Mootsikapun P, Wuthiekanun V, Teerawatasook N, Lulitanond A. Risk factors for melioidosis and bacteremic melioidosis. Clinical Infectious Diseases 1999; 29: 408-413.
22. Le Hello S, Currie BG, D, Spratt B, Mikulski M, Lacassin F, Garin B. Melioidosis in New Caledonia. Emerging Infectious Diseases 2005; 11: 1607-1609.
23. Inglis T, Rolim D, De Queiroz Sousa A. Melioidosis in the Americas. American Journal of Tropical Medicine and Hygiene 2006; 75: 947-954.
24. Gal DM, Mayo M, Smith-Vaughan HD, Dasari P, McKinnon M, Jacups SU, Urquhart AI, Hassel M, Currie B. Contamination of hand wash detergent linked to occupationally acquired melioidosis. American Journal of Tropical Medicine and Hygiene 2004; 71: 360-362.
25. Currie B. Melioidosis: an Australian perspective of an emerging infectious disease. In: V. Asche (Ed.). Recent Advances in Microbiology. Melbourne: Australian Society for Microbiology, 2000.
26. Peacock S, Schweizer H, Dance D, Smith T, Gee J, Wuthiekanun V, et al. Management of accidental laboratory exposure to Burkholderia pseudomallei and B. mallei. Emerging Infectious Diseases 2008; 14: e2.
27. Lumbiganon P, Viengnondha S. Clinical manifestations of melioidosis in children. Pediatric Infectious Disease Journal 1995; 14: 136-140.
28. Short B. Melioidosis: an important emerging infectious disease - a military problem? ADF Health 2002; 3: 13-21.
29. Howe C, Sampath A, Spotnitz M. The Pseudomallei group: a review. The Journal of Infectious Diseases 1971; 124: 598-606.
30. Leelarasamee A, Bovornkitti S. Melioidosis: review and update. Reviews of Infectious Diseases 1989; 11: 413-425.
31. Punyagupta S. Melioidosis. Review of 686 cases and presentation of a new clinical classification. In: S Punyagupta, T Sirisanthana, B Stapatayavong (Eds). Melioidosis. Bangkok: Bangkok Medical Publisher, 1989.
32. Limmathurotsakul D, Peacock S. Melioidosis: a clinical overview. British Medical Bulletin 2001; 99: 125-139.
33. Wuthiekanun V, Chierakul W, Langa S, Chaowagul W, Panpitpat C, Saipan P, et al. Development of antibodies to Burkholderia pseudomallei during childhood in melioidosis-endemic northeast Thailand. American Journal of Tropical Medicine and Hygiene 2006; 74: 1074-1075.
34. Currie B, Fisher D, Anstey N, Jacups S. Melioidosis: acute and chronic disease, relapse and re-activation. Transactions of the Royal Society of Tropical Medicine and Hygiene 2000; 94: 301-304.
35. Ngauy V, Lemeshev Y, Sadkowski L, Crawford G. Cutaneous melioidosis in a man who was taken as a prisoner of war by the Japanese during world war II. Journal of Clinical Microbiology 2005; 43: 970-972.
36. Gibney K, Cheng A, Currie B. Cutaneous melioidosis in the tropical top end of Australia: a prospective study and review of the literature. Clinical Infectious Diseases 2008; 47: 603-609.
37. Tan J, Yip S, Png D, Moorthy P. Primary melioidotic prostatic abscess: presentation, diagnosis and management. ANZ Journal of Surgery 2002; 72: 408-410.
38. Meumann E, Cheng A, Ward L, Currie B. Clinical features and epidemiology of melioidosis pneumonia: results from a 21-year study and review of the literature. Clinical Infectious Diseases 2012; 54: 362-369.
39. Morse L, Moller C, Harvey E, Ward L, Cheng A, Carson A, et al. Prostatic abscess due to Burkholderia pseudomallei: 81 cases from a 19-year prospective melioidosis study. Journal of Urology 2009; 182: 542-547.
40. Chan K, Low J, Raghuram J, Fook-Chong S, Kurup A. Clinical characteristics and outcome of severe melioidosis requiring intensive care. Chest 2005; 128: 3674-3678.
41. Dhiensiri T, Puapairoj S, Susaengrat W. Pulmonary melioidosis: clinical-radiologic correlation in 183 cases in northeastern Thailand. Radiology 1988; 166: 711-715.
42. Ip M, Osterberg L, Chau P, Raffin T. Pulmonary melioidosis. Chest 1995; 108: 1420-1424.
43. Malczewski A, Oman K, Norton R, Ketheesan N. Clinical presentation of melioidosis in Queensland, Australia. Transactions of the Royal Society of Tropical Medicine and Hygiene 2005; 99: 856-860.
44. Currie B. Melioidosis: an important cause of pneumonia in residents of and travellers returned from endemic regions. European Respiratory Journal 2003; 22: 542-550.
45. Mukhopadhyay A, Lee K, Tambyah P. Bacteraemic melioidosis pneumonia: impact on outcome, clinical and radiological features. Journal of Infection 2004; 48: 334-338.
46. Vietri N, Deshazer D. Melioidosis. In: Medical Aspects of Biological Warfare. Textbook of Military Medicine series. Washington, DC: TMM Publications, 2007; chapter 7.
47. Bondi SK, Goldberg GB. Strategies toward vaccines against Burkholderia mallei and Burkholderia pseudomallei. Expert Review of Vaccines 2008; 7: 1357-1365.
48. Aldhous P. Tropical medicine: Melioidosis? Never heard of it ... Nature 2005; 434: 692-693.
49. Limmathurotsakul D, Wuthiekanun V, Chierakul W, Cheng A, Maharjan B, Chaowagul W, et al. Role and significance of quantitative urine cultures in diagnosis of melioidosis. Journal of Clinical Microbiology 2005; 43: 2274-2276.
50. Veld D, Wuthiekanun V, Cheng A, Chierakul W, Chaowagul W, Brouwer A, et al. The role and significance of sputum cultures in the diagnosis of melioidosis. American Journal of Tropical Medicine and Hygiene 2005; 73: 657-661.
51. Wuthiekanun V, Supputtamongkol Y, Simpson A, Kanaphon P, White N. Value of throat swab in diagnosis of melioidosis. Journal of Clinical Microbiology 2001; 39: 3801-3802.
52. Chong V, Fan Y. The radiology of melioidosis. Australasian Radiology 1996; 40(3): 244-249.
53. Lim K, Chong V. Radiological manifestations of melioidosis. Clinical Radiology 2010; 65: 66-72.
54. Inglis T, Merritt A, Chidlow G, Aravena-Roman M, Harnett G. Comparison of diagnostic laboratory methods from the identification of Burkholderia pseudomallei. Journal of Clinical Microbiology 2005; 43: 2201-2206.
55. Hodgson K, Engler C, Govan B, Ketheesan N, Norton R. Comparison of routine bench and molecular diagnostic methods in identification of Burkholderia pseudomallei. Journal of Clinical Microbiology 2009; 47: 1578-1580.
56. Ashdown L. An improved screening technique for the isolation of Pseudomonas pseudomallei from clinical specimens. Pathology 1979; 11: 293-297.
57. Cheng A, Wuthiekanun V, Limmathurotsakul D, Wongsuvan G, Day N, Peacock S. Role of selective and non-selective media in the isolation of Burkholderia pseudomallei from throat swabs of patients with melioidosis. Journal of Clinical Microbiology 2006; 44: 2316.
58. Francis A, Aiyar S, Yean C, Naing L, Ravichandran M. An improved selective and differential medium for the isolation of Burkholderia pseudomallei from clinical specimens. Diagnostic Microbiology and Infectious Disease 2006; 55: 95-99.
59. Glass M, Popovic T. Preliminary evaluation of the API 20NE and RapID NF plus systems for rapid identification of Burkholderia pseudomallei and B. mallei. Journal of Clinical Microbiology 2005; 43: 479-483.
60. Peacock S, Chieng G, Cheng A, Dance D, Amornchai P, Wongsuvan G, et al. Comparison of Ashdown's medium, Burkholderia cepacia medium, and Burkholderia pseudomallei selective agar for clinical isolation of Burkholderia pseudomallei. Journal of Clinical Microbiology 2005; 43: 5359-5361.
61. Amornchai P, Chierakul W, Wuthiekanun V, Mahakhunkijcharoen Y, , Phetsouvanh R, Currie B, et al. Accuracy of Burkholderia pseudomallei identification using the API 20NE system and a latex agglutination test. Journal of Clinical Microbiology 2007; 43: 479-483.
62. Glass M, Beesley C, Wilkins P, Hoffmaster A. Comparison of four selective media for the isolation of Burkholderia mallei and Burkholderia pseudomallei. American Journal of Tropical Medicine and Hygiene 2009; 8, ,,, , 0, : 1023-1028.
63. Kiratisin P, Santanirand P, Chantratita N, Kae, wdaeng S. Accuracy of commercial systems for identification , of Burkho, ld, eria pseudomallei versus Burkholderia cep, acia. Diagnostic Microbiology and Infectious Disease 2007; 59: 277-281.
64. Inglis TH, PE Fremlin, LJ Golledge, CL. Short report: use of matrix-assisted laser-desorption ionization-time of flight mass spectrometry analysis for rapid confirmation of Burkholderia pseudomallei in septicemic melioidosis. American Journal of Tropical Medicine and Hygiene 2012; 86: 1039-1042.
65. Glass MB, Steigerwalt AG, Jordan JG, Wilkins PP, Gee JE. Burkholderia oklahomensis sp. nov., a Burkholderia pseudomallei-like species formerly known as the Oklahoma strain of Pseudomonas pseudomallei. International Journal of Systematic and Evolutionary Microbiology 2006; 56: 2171-2176.
66. Brett PJ, DeShazer D, Woods DE. Burkholderia thailandensis sp. nov., a Burkholderia pseudomallei-like species. International Journal of Systematic Bacteriology 1998; 48: 317-320.
67. Smith MD, Angus BJ, Wuthiekanun V, White NJ. Arabinose assimilation defines a nonvirulent biotype of Burkholderia pseudomallei. Infection and Immunity 1997; 65: 4319-4321.
68. Häuβler S, Rohde M, Steinmetz I. Highly resistant Burkholderia pseudomallei small colony variants isolated in vitro and in experimental melioidosis. Medical Microbiology and Immunology 1999; 188: 91-97.
69. Chantratita N, Rholl D, Sim B, Wuthiekanun V, Limmathurotsakul D, Amornchai P, et al. Antimicrobial resistance to ceftazidime involving loss of penicillin-binding protein 3 in Burkholderia pseudomallei. Proceedings of the National Academy of Sciences USA 2011; 108: 17165-17170.
70. Merritt A, Inglis T, Chidlow G, Harnett G. PCR-based identification of Burkholderia pseudomallei. Revista do Instituto de Medicina Tropical de São Paulo 2006; 48: 239-44.
71. Supaprom C, Wang D, Leelayuwat C, Thaewpia W, Susaengrat W, Koh V, et al. Development of real-time PCR assays and evaluation of their potential use for rapid detection of Burkholderia pseudomallei in clinical blood specimens. Journal of Clinical Microbiology 2007; 45: 2894-2901.
72. Thibault F, Valade E, Vidal D. Identification and discrimination of Burkholderia pseudomallei, B. mallei, and B. thailandensis by real-time PCR targeting type III secretion system genes. Journal of Clinical Microbiology 2004; 42: 5871-5874.
73. Peacock S, Cheng A, Currie B, Dance D. The use of positive serological tests as evidence of exposure to Burkholderia pseudomallei. American Journal of Tropical Medicine and Hygiene 2011; 84: 1021-1022.
74. Cheng A, O'Brien M, Freeman K, Lum G. Indirect hemagglutination assay in patients with melioidosis in northern Australia. American Journal of Tropical Medicine and Hygiene 2006; 74: 330-334.
75. Smith M, Wuthiekanun V, Walsh A, Teerawattanasook N, Desakorn V, Supputtamongkol Y, et al. Latex agglutination for rapid detection of Pseudomonas pseudomallei antigen in urine of patients with melioidosis. Journal of Clinical Pathology 1995; 48: 174-176.
76. Puthucheary S, Anua A, Tee T. Burkholderia thailandensis whole cell antigen cross-reacts with B. pseudomalllei antibodies from patients with melioidosis in an immunofluorescent assay. Southeast Asian Journal of Tropical Medicine and Public Health 2010; 41: 395-400.
77. Walsh A, Smith M, Wuthiekanun V, Supputtamongkol Y, Desakorn V, Chaowagul W, et al. Immunofluorescence microscopy for the rapid diagnosis of melioidosis. Journal of Clinical Pathology 1994; 47: 377-379.
78. Wuthiekanun V, Desakorn V, Wongsuvan G, Amornchai P, Cheng A, Maharjan B, et al. Rapid immunofluorescence microscopy for diagnosis of melioidosis. Clinical and Diagnostic Laboratory Immunology 2005; 12: 555-556.
79. Dharakul T, Songsivilai S, Smithikarn S, Thepthai C, Leelaporn A. Rapid identification of Burkholderia pseudomallei in blood cultures by latex agglutination using lipopolysaccharide-specific monoclonal antibody. American Journal of Tropical Medicine and Hygiene 1999; 61: 658-662
80. Lowe P, Engler C, Norton R. Comparison of automated and nonautomated systems for identification of Burkholderia pseudomallei. Journal of Clinical Microbiology 2002; 40: 4625-4627.
81. Anuntagool N, Naigowit P, Petkanchanapong V, Aramsri P, Panichakul T, Sirisinha S. Monoclonal antibody-based rapid identification of Burkholderia pseudomallei in blood culture fluid from patients with community-acquired septicaemia. Journal of Medical Microbiology 2000; 49: 1075-1078.
82. Bauernfeind A, Roller C, Meyer D, Jungwirth R, Schneider I. Molecular procedure for rapid detection of Burkholderia mallei and Burkholderia pseudomallei. Journal of Clinical Microbiology 1998; 36: 2737-2741.
83. Samosornsuk N, Lulitanond A, Saenla N, Anuntagool N, Wongratanacheewin S, Sirisinha S. Short report: evaluation of a monoclonal antibody-based latex agglutination test for rapid diagnosis of septicemic melioidosis. American Journal of Tropical Medicine and Hygiene 1999; 61: 735-737.
84. Kaestli M, Richardson LJ, Colman RE, Tuanyok A, Price EP, Bowers JR, et al. Comparison of TaqMan PCR assays for detection of the melioidosis agent Burkholderia pseudomallei in clinical specimens. Journal of Clinical Microbiology 2012; 50: 2059-2062.
85. Price EP, Dale JL, Cook JM, Sarovich DS, Seymour ML, Ginther JL, et al. Development and validation of Burkholderia pseudomallei-specific real-time PCR assays for clinical, environmental or forensic detection applications. PloS One 2012; 7: e37723.
86. Janse I, Hamidjaja RA, Hendriks AC, van Rotterdam BJ. Multiplex qPCR for reliable detection and differentiation of Burkholderia mallei and Burkholderia pseudomallei. BMC Infectious Diseases 2013; 13: 86.
87. Lowe W, March JK, Bunnell AJ, O'Neill KL, Robison RA. PCR-based methodologies used to detect and differentiate the Burkholderia pseudomallei complex: B. pseudomallei, B. mallei, and B. thailandensis. Current Issues in Molecular Biology 2013; 16: 23-54.
88. Lau SKP, Tang BSF, Curreem SOT, Chan TM, Martelli P, Tse CWS, et al. Matrix-assisted laser desorption ionization-time of flight mass spectrometry for rapid identification of Burkholderia pseudomallei: importance of expanding databases with pathogens endemic to different localities. Journal of Clinical Microbiology 2012; 50: 3142-3143.
89. Inglis T. The treatment of melioidosis. Pharmaceuticals 2010; 3: 1296-1303.
90. Wuthiekanun V, Peacock S. Management of melioidosis. Expert Review of Anti-infective Therapy 2006; 4: 445-455.
91. White N, Chaowagul W, Wuthiekanun V, Dance D, Wattanagoon Y, Pitakwatchara N. Halving of mortality of severe melioidosis by ceftazidime. Lancet 1989; 334: 697-701.
92. Suputtamongkol Y, Rajanuwong A, Chaowagul W, Dance D, Smith M, Wuthiekanun V, et al. Ceftazidime vs amoxicillin/clavulanate in the treatment of severe melioidosis. Clinical Infectious Diseases 1994; 19: 846-853.
93. Chierakul W, Anunnatsiri S, Short J, Maharjan B, Mootsikapun P, Simpson A, et al. Two randomized controlled trials of ceftazidime alone versus ceftazidime in combination with trimethoprim-sulfamethoxazole for the treatment of severe melioidosis. Clinical Infectious Diseases 2005; 15: 1105-1113.
94. Chierakul W, Anunnatsiri S, Chaowagul W, Peacock S, Chetchotisakd P, Day N. Addition of trimethoprim-sulfamethoxazole to ceftazidime during parenteral treatment of melioidosis is not associated with a long-term outcome benefit. Clinical Infectious Diseases 2007; 15: 521-523.
95. Thamprajamchit S, Chetchotisakd P, Thinkamrop B. Cefoperazone/sulbactam + co-trimoxazole vs ceftazidime + co-trimoxazole in the treatment of severe melioidosis: a randomized, double-blind, controlled study. Journal of the Medical Association of Thailand 1998; 81: 265-271.
96. Samuel M, Ti T. Interventions for treating melioidosis. Cochrane Database of Systematic Reviews 2002; 4: CD001263.
97. Thibault F, Hernandez E, Vidal D, Girardet M, Cavallo J. Antibiotic susceptibility of 65 isolates of Burkholderia pseudomallei and Burkholderia mallei to 35 antimicrobial agents. Journal of Antimicrobial Chemotherapy 2004; 54: 1134-1138.
98. Dance D, Wuthiekanun V, Chaowagul W, White N. The antimicrobial susceptibility of Pseudomonas pseudomallei. Emergence of resistance in vitro and during treatment. Journal of Antimicrobial Chemotherapy 1989; 24: 295-309.
99. Jenney A, Lum G, Fisher D, Currie B. Antibiotic susceptibility of Burkholderia pseudomallei from tropical northern Australia and implications for therapy of melioidosis. International Journal of Antimicrobial Agents 2000; 17: 109-13.
100. Lumbiganon P, Panamonta O. Imipenem therapy for septicemic melioidosis in a child with penicillin and cephalosporin adverse reaction. Southeast Asian Journal of Tropical Medicine and Public Health 2000; 31: 89-90.
101. Lumbiganon P, Saengsa-Ard S, Wilailuckana C. Imipenem therapy for melioidosis in two children. Pediatric Infectious Disease Journal 1992; 11: 414-416.
102. Cheng A, Fisher D, Anstey N, Stephens D, Jacups S, Currie B. Outcomes of patients with melioidosis treated with meropenem. Antimicrobial Agents and Chemotherapy 2004; 48: 1763-1765.
103. Simpson A, Suputtamongkol Y, Smith M, Angus B, Rajanuwong A, Wuthiekanun V, et al. Comparison of imipenem and ceftazidime as therapy for severe melioidosis. Clinical Infectious Diseases 1999; 29: 381-387.
104. Huffam S, Jacups S, Kittler P, Currie B. Out of hospital treatment of patients with melioidosis using ceftazidime in 24 h elastomeric infusors, via peripherally inserted central catheters. Tropical Medicine and International Health 2004; 9: 715-717.
105. Suputtamongkol Y, Dance D, Chaowagul W, Wattanagoon Y, Wuthiekanun V, White N. Amoxycillin-clavulanic acid treatment of melioidosis. Transactions of the Royal Society of Tropical Medicine and Hygiene 1991; 85: 672-675.
106. Chetchotisakd P, Chaowagul W, Mootsikapun P, Budhsarawong D, Thinkamrop B. Maintenance therapy of melioidosis with ciprofloxacin plus azithromycin compared with cotrimoxazole plus doxycycline. American Journal of Tropical Medicine and Hygiene 2001; 64: 24-27.
107. Chierakul W, Wangboonskul J, Singtoroj T, Pongtavornpinyo W, Short J, Maharjan B, et al. Pharmacokinetic and pharmacodynamic assessment of co-amoxiclav in the treatment of melioidosis. Journal of Antimicrobial Chemotherapy 2006; 58: 1215-1220.
108. Dance D, Wuthiekanun V, Chaowagul W, Suputtamongkol Y, White N. Development of resistance to ceftazidime and co-amoxiclav in Pseudomonas pseudomallei. Journal of Antimicrobial Chemotherapy 1991; 28: 321-324.
109. Lumbiganon P, Tattawasatra U, Chetchotisakd P, Wongrattanacheewin S, Thinkhamrop B. Comparison between the antimicrobial susceptibility of Burkholderia pseudomallei to trimethoprim-sulfamethoxazole by standard disk diffusion method and by minimal inhibitory concentration determination. Journal of the Medical Association of Thailand 2000; 83: 856-860.
